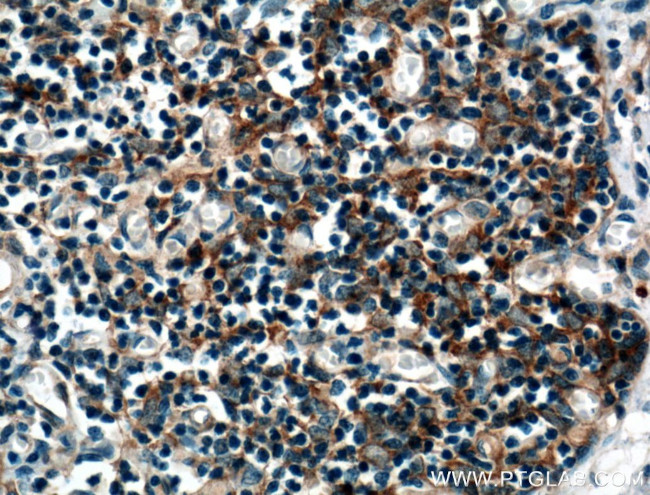
AFAP1L2 Antibody in Immunohistochemistry (Paraffin) (IHC (P))

Search
Proteintech
AFAP1L2 Polyclonal Antibody
{{$productOrderCtrl.translations['antibody.pdp.commerceCard.promotion.promotions']}}
{{$productOrderCtrl.translations['antibody.pdp.commerceCard.promotion.viewpromo']}}
{{$productOrderCtrl.translations['antibody.pdp.commerceCard.promotion.promocode']}}: {{promo.promoCode}} {{promo.promoTitle}} {{promo.promoDescription}}. {{$productOrderCtrl.translations['antibody.pdp.commerceCard.promotion.learnmore']}}
产品信息
17183-1-AP
种属反应
已发表种属
宿主/亚型
分类
类型
抗原
偶联物
形式
浓度
规格
纯化类型
保存液
内含物
保存条件
运输条件
产品详细信息
Immunogen sequence: SCIVSAAKN SLLLMQRKFS EPNTYIDGLP SQDRQEELYD DVDLSELTAA VEPTEEATPV ADDPNERESD RVYLDLTPVK SFLHGPSSAQ AQASSPTLSC LDNATEALPA DSGPGPTPDE PCIKCPENLG EQQLESLEPE DPSLRITTVK IQTEQQRISF PPSCPDAVVA TPPGASPPVK DRLRVTSAEI KLGKNRTEAE VKRYTEEKER LEKKKEEIRG HLAQLRKEKR ELKETLLKCT DKEVLASLEQ KLKEIDEECR GEESRRVDLE LSIMEVKDNL KKAEAGPVTL GTTVDTTHLE NVSPRPKAVT PASAPDCTPV NSATTLKNRP LSVVVTGKGT VLQKAKEWEK KGAS (466-818 aa encoded by B C033212)
靶标信息
AFAP1L2, also known as XB130, is structurally similar to actin-filament-associated protein (AFAP), containing several SH2- and SH3-binding motifs, two pleckstrin homology domains, a coiled-coil region, and many potential phosphorylation sites. It interacts with and is phosphorylated by c-Src tyrosine kinase. Suppression of AFAP1L2 via siRNA reduced Src activity, IL-8 production, EGF-induced phosphorylation of Akt and GSK3beta, and altered cell cycles in human lung epithelial cells suggesting that AFAP1L2 plays a role as an adaptor in the regulation of Src signal transduction and multiple cellular functions. Recent experiments have shown that AFAP1L2 is highly expressed in thyroid and is the substrate RET/PTC kinase, a thyroid-specific kinase that plays a pathogenic role in papillary thyroid cancer. Down-regulation of AFAP1L2 in these cancer cells reduced Akt activity, inhibiting cell-cycle progression and cancer cell survival in suspension, indicating that AFAP1L2 may be a valuable target in thyroid cancer therapy. At least four isoforms of AFAP1L2 are known to exist.
仅用于科研。不用于诊断过程。未经明确授权不得转售。
生物信息学
蛋白别名: Actin filament-associated protein 1-like 2; adaptor protein for Src binding and activation; AFAP1-like protein 2; CTB-1144G6.6; unnamed protein product
基因别名: AFAP1L2; AU041783; C86904; CTB-1144G6.4; KIAA1914; mKIAA1914; XB130
UniProt ID: (Human) Q8N4X5, (Mouse) Q5DTU0
Entrez Gene ID: (Human) 84632, (Mouse) 226250